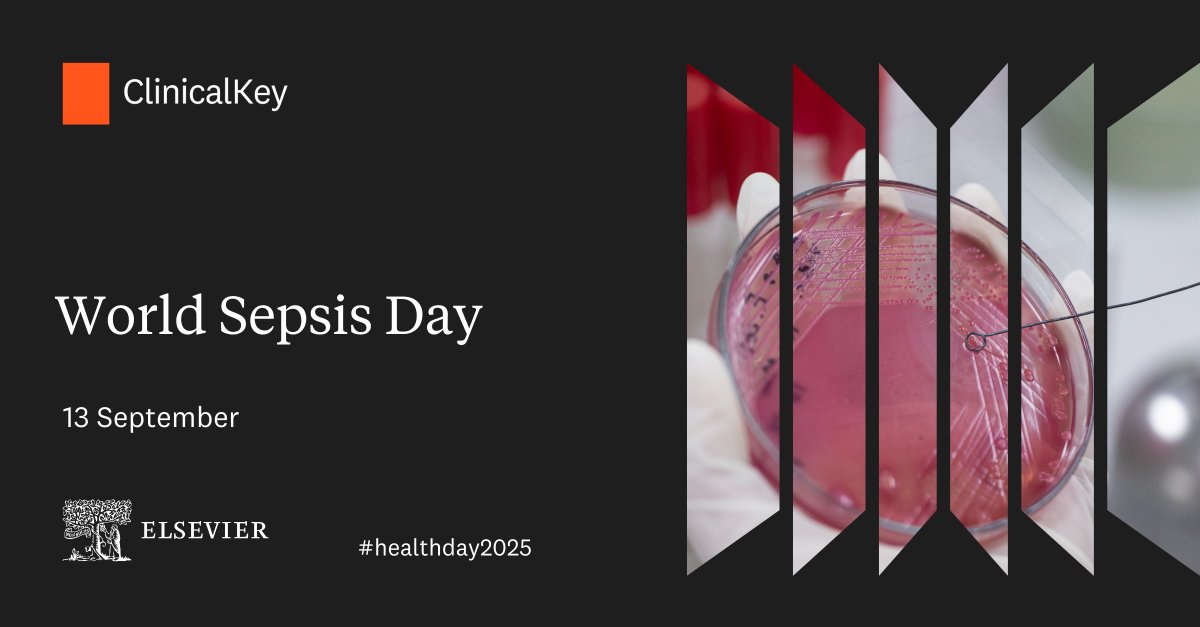

NUH Library Services
@nuhlibrary
NHS multidisciplinary library supporting medical education, evidence-based practice, professional development & research.
Also on Instagram @NUHLibrary
ID: 2647429268
https://www.nuh.nhs.uk/nuh-library-services 15-07-2014 11:23:11
6,6K Tweet
1,1K Takipçi
2,2K Takip Edilen

Our Out of Hours Service is back up and running this evening from 5pm. If you are a member of NUH staff and interested in 24/7 access to City Library, please e-mail us at [email protected] for more information. Nottingham University Hospitals PMED at NUH City & QMC


Diabetes affects millions worldwide, posing serious health risks and complications if left unmanaged. This #DiabetesWeek, use Elsevier | ClinicalKey to find evidence-based resources to help you identify, diagnose & treat your patients. Available with your NUH OpenAthens account. 🔍



#WorldSickleCellAwarenessDay highlights the urgent need for access to comprehensive care & essential treatments for individuals living with sickle cell disease. Explore in-depth guidance on diagnosis & management Elsevier | ClinicalKey by logging in with your NUH OpenAthens account. 📑





🌍 🧠 Today is World Brain Day 🧠 🌍 Managing neurological & mental health conditions requires ongoing medical support & preventive strategies to improve a patient's quality of life. Access Elsevier | ClinicalKey with OpenAthens for resources to help with your clinical practice.





Just a quick reminder that City Library will be closed to all users (including those with out of hours access) this Bank Holiday weekend from 5pm tonight. We will reopen at 9am on Tuesday 26th August. ⛔️ Nottingham University Hospitals PMED at NUH City & QMC NUH Medicine NUH Nursing NUH Admin & Management NUH Allied Health Professionals

City Library will be closed to all users this weekend from 5pm tonight until 9am Monday 1st September. Study space at the D Floor Learning Hub at QMC will still be available if you have requested access. Nottingham University Hospitals PMED at NUH City & QMC NUH Medicine NUH Nursing NUH Admin & Management NUH Allied Health Professionals



🌍 🩸 Tomorrow is World Sepsis Day. 🩸 🌍 Early recognition and treatment are crucial for survival with this life-threatening condition. Use your NUH OpenAthens account Elsevier | ClinicalKey to access the latest medical research to improve patient care. NUH Critical Care🏳️🌈

October is #BreastCancerAwarenessMonth: a time to raise awareness, promote early detection, & support ongoing care for those affected. Use your NUH OpenAthens account Elsevier | ClinicalKey to search for the latest in breast cancer research - clinicalkey.com. 💻

